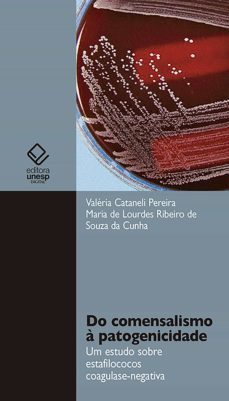
do comensalismo a patogenicidade (ebook)-valeria cataneli pereira-maria lourdes ribeiro souza de de da cunha-9788568334188

eBooks de Biología, página 35 de 130
SANZ GARCÍA, JOSÉ LUIS
Editorial Crítica 9788491995937
eBook
PONTAL, MARCOS
Clube de Autores 3410006774510
eBook
ANELLI, LUIZ E.
Editora Peirópolis 9788575964217
eBook
Timothy Franceschi 9788826463223
eBook
CRITICA 9788491992998
eBook
DOS NASCENTE, ORG. ROGER RODRIGO SANTOS - ED. ADRIANO STEPHAN
Clube de Autores 9786599598623
eBook
RILEY, CHARLES V.
Good Press 4064066171940
eBook
HUXLEY, THOMAS HENRY
Good Press 4064066213282
eBook
MEDRADRO, VITOR
Editora Dialética 9786527076322
eBook
CIENTÍFICO, O
Clube de Autores 3410003668126
eBook
WARD, H. MARSHALL
Good Press 4064066236571
eBook
BONDE, CECIL VON y GILCHRIST, J. D. F.
DigiCat 8596547357063
eBook
GILCHRIST, J. D. F. y BONDE, CECIL VON
Good Press 4064066137953
eBook
IMM Lifestyle Books 9781607653622
eBook
Companhia de Bolso 9788580865080
eBook
ZAGO, MANECO
Clube de Autores 9786526615027
eBook
PEREIRA, VALERIA CATANELI y DE DE DA CUNHA, MARIA LOURDES RIBEIRO SOUZA
Editora Unesp 9788568334188
eBook
COSTA, LUCIANA y FINOTTI, RICARDO
Freitas Bastos 9786556754949
eBook
DELUCIA, ROBERTO
Clube de Autores 3410002047878
eBook
Edizioni L'Erta 9791223029770
eBook